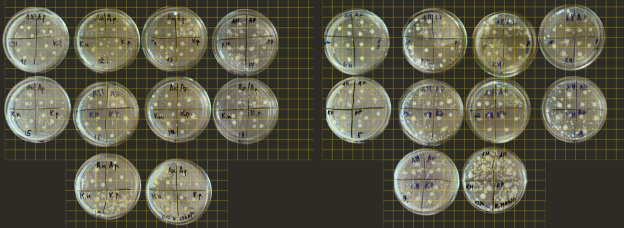
Измерение результатов методом палетки в Группе «Этанол» и «Масло»

В сезон острых респираторных заболеваний мы чаще всего используем привычные лекарственные препараты и не задумываемся о побочных эффектах, которые могут наблюдаться при их приеме. Кроме того, микроорганизмы со временем вырабатывают резистентность к фармацевтическим препаратам, и лечение становится неэффективным.
Наши родители в период сезонных заболеваний часто используют дома диффузор, в который капают эфирные масла, а также карандаши для ингаляций, которые нам дают с собой на занятия. Нам стало интересно, действительно ли природные средства могут эффективно защищать нас от микроорганизмов, вызывающих заболевания.
В нашей работе мы планируем получить эфирные масла из наиболее доступных нам сортов эфиромасличных растений, а также проверить, какие сорта проявляют наиболее высокую антимикробную активность.
Цель работы: оценить антимикробную активность эфирных масел, полученных из разных сортов базилика, мяты и тимьяна.
Объект исследования: эфирные масла, полученные из разных сортов базилика, мяты, тимьяна.
Предмет исследования: влияние эфирных масел на микроорганизмы.
Гипотеза научной работы: мы предполагаем, что эфирные масла, полученные из разных сортов базилика, мяты, тимьяна, обладают различной антимикробной активностью.
Актуальность. Эфирные масла более доступны, обладают антимикробными свойствами, а микроорганизмы при длительном контакте с эфирными маслами практически не вырабатывают устойчивость к ним. Все это позволяет рассматривать использование эфирных масел в качестве профилактики и лечения различных заболеваний.
Практическая значимость. Результаты нашей исследовательской работы могут быть использованы для выбора эффективных эфирных масел для профилактики и лечения острых респираторных заболеваний, а также для информирования школьников об антимикробных свойствах эфирных масел и их доступности.
Особенности эфирных масел
Эфирные масла — летучие соединения с характерным сильным запахом. Они вырабатываются только растениями и имеют в своем составе более 500 химических веществ. В настоящее время насчитывается около 3 000 видов растений, пригодных для получения эфирных масел. Эфиромасличным может быть как все растение целиком, так и какая-то определенная его часть: стебли, корни, плоды, семена, соцветия, цветы, хвоя, листья, древесина. [12]
Эфирные масла отличаются от жирных (подсолнечное, оливковое и др.) тем, что улетучиваются при нормальной температуре и не оставляют пятен на бумаге. Они растворяются в спирте, эфире, жирных маслах, но не растворяются в воде. [7]
История применения
Человечество знакомо с лечебным действием эфирных масел более 6 000 лет. Они активно применялись в древних цивилизациях — Египте, Персии, Китае и Индии. Древние народы использовали эфирные масла для бальзамирования тел усопших, проведения религиозных обрядов, лечения различных заболеваний. Масла входили в состав мазей, пилюль и бальзамов. В быту масла служили для ароматизации продуктов питания, одежды и предметов обихода. [2]
В средние века ароматические масла применяли для дезинфекции помещений, нужд парфюмерии и борьбы с эпидемиями, такими, как чума, холера и туберкулёз. Во время Первой мировой войны эфирные масла нашли применение в военных госпиталях. В 1937 году французский химик Рене-Моррис Гаттефосе ввел термин «ароматерапия» после того, как вылечил ожог лавандовым маслом. Позже, в связи развитием производства синтетических лекарственных препаратов использование эфирных масел сократилось. [9]
Сегодня проблема устойчивости бактерий к синтетическим антибиотикам становится всё более актуальной. По данным Всемирной организации здравоохранения (ВОЗ), резистентность микроорганизмов к противомикробным препаратам угрожает глобальному здравоохранению. В этой связи растёт интерес к природным антибактериальным средствам, в том числе к эфирным маслам. [3, 4].
В настоящее время эфирные масла стали частью натуральной косметики и интегративной медицины, сочетая древние традиции с научными исследованиями.
Основные методы получения эфирных масел
Выбор метода производства эфирных масел определяется типом сырья, назначением продукта и экономическими факторами. У каждого метода есть свои преимущества и недостатки, а эфирные масла, полученные разными способами, имеют различные свойства.
Прессование (холодный отжим) — метод в основном подходит для цитрусовых (апельсин, бергамот, лимон). Масло выдавливается из кожуры без термической обработки, что сохраняет натуральный аромат.
Дистилляция (перегонка с водяным паром) — через растительное сырье пропускают горячий пар под давлением. Пар увлекает летучие эфирные масла. Затем смесь охлаждается и конденсируется в жидкость. Поскольку эфирное масло не смешивается с водой, его легко отделить.
Экстракция растворителями — сырьё обрабатывают спиртами, эфирами или другими растворителями, которые извлекают ароматические соединения. Затем растворитель удаляют, оставляя концентрированное масло.
Мацерация — растительное сырьё погружают в нагретое базовое масло (подсолнечное, оливковое). При этом клеточные структуры разрушаются, и ароматические вещества переходят в масло. Затем сырье отфильтровывают. Один из древнейших способов.
Анфлераж — трудоёмкий и дорогостоящий метод для деликатного сырья. Лепестки выкладывают на стеклянные пластины, покрытые очищенным жиром. Жир абсорбирует эфирные масла, образуя «ароматическую помаду». Затем её экстрагируют спиртом, получая высококонцентрированный продукт — абсолют.
Адсорбция активированным углём — современный метод: пары эфирных масел поглощаются углём, после чего масло извлекают спиртовой экстракцией. Позволяет получить чистый продукт. [10]
Свойства эфирных масел
Антимикробное и противовирусное — это одно из самых сильных и научно подтвержденных свойств. Эфирные масла в сравнении с синтетическими лекарственными препаратами обладают более широким спектром действия и практически полным отсутствием побочных явлений. При длительном контакте с маслами микроорганизмы не вырабатывают к ним устойчивости, что является существенным преимуществом перед антибиотиками и другими лекарственными препаратами. [8, 6]. Масла с выраженными антимикробными свойствами: чайное дерево, эвкалипт, гвоздика, базилик, тимьян, мята, мелисса, лаванда, герань.
Противовоспалительное и обезболивающее — многие масла способны снижать выработку медиаторов воспаления и обладают легким анальгезирующим эффектом (ромашка, мята, лаванда, имбирь, майоран).
Психоэмоциональное воздействие (основа ароматерапии) — аромат напрямую влияет на отделы головного мозга, которые отвечают за эмоции (ромашка, лаванда, лимон, мята, базилик, мандарин, жасмин, сандал, бергамот, и т. д.).
Регенерирующее — стимулируют обновление клеток, улучшают состояние кожи (лаванда, чайное дерево, мирра, герань, нероли).
Общеукрепляющее — повышают сопротивляемость организма (ладан, чайное дерево, эвкалипт, сосна, лимон).
Применение эфирных масел
Медицина и фармакология — как поддерживающее средство при лечении ОРВИ, воспалительных процессов, для ускорения заживления ран и ожогов. В качестве активного компонента в сиропах от кашля, мазях, пластырях.
Пищевая промышленность и кулинария — применяются как натуральные консерванты, ароматизаторы для придания вкуса и запаха напиткам, соусам, кондитерским изделиям, добавляют в мясные продукты для подавления роста бактерий.
В парфюмерии и косметологии — добавление в качестве отдушек в парфюмерные ароматы, а также в качестве активных веществ в кремы и лосьоны и сыворотки для ухода за кожей и волосами.
Бытовая химия — как ароматизаторы и дезинфицирующие компоненты в экологичных средствах для мытья посуды, полов, поверхностей. В спреях и кремах от комаров, клещей, моли.
Сельское хозяйство — в органическом земледелии для защиты растений от вредителей и грибков.
Хобби и творчество — в мыловарении, создании свечей и т. д.
Ароматерапия — добавление в аромалампы и диффузоры.
Несмотря на все плюсы эфирных масел и широкое применение, необходимо помнить, что эфирные масла — это высококонцентрированные активные вещества и их бесконтрольное применение не безобидно. Их использование требует ответственного и информированного подхода к дозировке и индивидуальным особенностям каждого организма.
Определение видов и сортов эфиромасличных растений для выращивания. Получение растительного сырья
В качестве сырья для изготовления эфирных масел мы выбрали три вида эфиромасличных растений: мята, базилик, тимьян. Основные критерии выбора: доступность вида, неприхотливость в выращивании и уходе, наличие антимикробных компонентов в составе эфирных масел, получаемых из предполагаемого растительного сырья. [10]. Для каждой культуры были выбраны три сорта, отличающихся по органолептическим свойствам: аромат, внешний вид. Растения подбирались с учетом Государственного реестра сортов и гибридов сельскохозяйственных растений [5]. Итоговый перечень растений и их свойства представлены в Таблице 1.
Таблица 1
Характеристики выбранных эфиромасличных растений
|
Вид |
Антимикр. вещество |
Описание |
Аромат |
|
Мята колосистая/ Медовая пасека |
Ментол |
80 см., лист темно-зеленый, с зазубренным краем. |
Ментоловый с медовой ноткой |
|
Мята овощная/ Ментол |
Ментол |
65 см., лист среднего размера, овальный, с зубчатым краем, зеленый. Облиственность высокая. |
Ментоловый насыщенный |
|
Мята длиннолистная |
Ментол |
50–60 см, лист длиной до 7 см, серебристо-зеленый с пильчатым краем, опушенный. |
Мятно-пряный |
|
Базилик овощной/ Арарат |
Эвгенол |
40–60 см, лист черешковый, среднего размера, широкояйцевидной формы с редко-зубчатым краем, синевато-зеленый. |
Анисовый |
|
Базилик овощной/ Лимончик |
Эвгенол |
40–45см, лист эллиптической формы, среднего размера, зеленый. Волнистость края отсутствует. |
Лимонный, насыщенный |
|
Базилик овощной/ Изумруд |
Эвгенол |
40–45см, лист широкояйцевидной формы, крупный, зеленый, пузырчатый, выпуклый. Волнистость края слабая. |
Гвоздичный |
|
Тимьян/ Лимонный |
Тимол, карвакрол |
20–25 см, лист ланцетовидной формы, мелкий, гладкий, зеленый. |
Лимонная нотка |
|
Тимьян овощной/ Медовый аромат |
Тимол, карвакрол |
20–30 см, лист мелкий, гладкий, темно-зеленый, ланцетовидной формы. |
Медовая нотка |
|
Тимьян овощной/ Ароматная грядка |
Тимол, карвакрол |
25–30 см, лист мелкий, гладкий, темно-зеленый, ланцетовидной формы. |
Пряный |
Посев семян был произведен 12 июня 2025 года в мини-парники с фитолампой. Всходы появились через 5 суток. Через 4 недели была произведена пикировка. Растения рассадили в ящики с системой прикорневого полива и переместили выращиваемые культуры на открытый стеллаж с естественным освещением. В процессе роста осуществляли регулярный полив (1–2 раза в неделю) и наблюдение за ростом растений. Через 4 месяца с момента посева в начале октября 2025 года до начала цветения растений мы произвели сбор листьев с выращиваемых культур для изготовления эфирных масел.
Изготовление эфирных масел
Для получения эфирных масел мы применили метод экстракции. Вкачестве экстрагентов мы взяли этиловый спирт (этанол) и рафинированное подсолнечное масло. Процесс изготовления эфирных масел был начат сразу после сбора сырья. Подготовленное растительное сырье мелко измельчили и разложили в 18 стеклянных емкостей (банок) по сортам растений. Далее в 9 из 18 банок добавили этанол в соотношении 1:4, где 1 — доля веса сырья, а 4 — доля этанола (группа «Этанол»). В остальные 9 банок было залито растительное масло в таком же соотношении (группа «Масло»). Банки с исследуемыми образцами были помещены в темное место на один месяц. В результате были получены 18 образцов эфирных масел (неочищенных и неотфильтрованных).
Определение антимикробной активности эфирных масел мяты, базилика, тимьяна
Для определения антимикробной активности эфирных масел мы использовали диско-диффузный метод , применяемый в медицине для определения чувствительности бактерий к различным антибиотикам. Принцип метода основан на способности антимикробного вещества проникать из пропитанных ими бумажных дисков в питательную среду, угнетая рост микроорганизмов, посеянных на поверхности агара.
В лаборатории лицея мы разлили питательную среду в чашки Петри и оставили для остывания. Спустя 30 минут мы нанесли образцы микроорганизмов, полученные из носовой и ротовой полости участников эксперимента на заранее размеченные зоны чашек Петри, и поместили на питательную среду диски, пропитанные образцами полученных эфирных масел. Также были засеяны 2 контрольные чашки Петри, в которые были помещены диски, пропитанные этиловым спиртом и рафинированным растительным маслом. Полученные 20 чашек Петри с посевами мы поместили в темное место при комнатной температуре. Через 48 часов рост микроорганизмов был достаточен для оценки результатов эксперимента.
Описание результатов
Основным критерием антимикробной активности стало определение зоны отсутствия роста микроорганизмов в засеянных чашках Петри вокруг дисков, пропитанных эфирными маслами базилика, мяты и тимьяна. Чем больше площадь данной зоны, тем выше антимикробная активность эфирного масла. Для измерения размера зон отсутствия роста микроорганизмов был использован метод палетки. (Рис. 1).
Рис. 1. Измерение результатов методом палетки в Группе «Этанол» и «Масло»
Итоговые результаты отсутствия роста микроорганизмов, переведенные в проценты, представлены в Таблице 2.
Таблица 2
Площадь зоны отсутствия роста микроорганизмов, %
|
Название (№ чашки Петри этанол, масло) |
Этанол, % |
Растительное масло, % |
|
Мята колосистая Медовая пасека, (11, 1) |
84 |
92 |
|
Мята овощная Ментол, (12, 2) |
88 |
48 |
|
Мята длиннолистная, (13, 3) |
80 |
44 |
|
Базилик Арарат, (14, 4) |
72 |
88 |
|
Базилик Лимончик, (15, 5) |
84 |
84 |
|
Базилик Изумруд, (16, 6) |
88 |
60 |
|
Тимьян Лимонный, (17, 7) |
96 |
80 |
|
Тимьян овощной Медовый аромат, (18, 8) |
88 |
68 |
|
Тимьян овощной Ароматная грядка, (19, 9) |
80 |
32 |
|
Контроль, (10, 20) |
12 |
8 |
На диаграмме (Рис. 2) видно, что контрольные образцы показали минимальную зону отсутствия роста микробов, что подтверждает наличие у всех используемых образцов эфирных масел антимикробной активности.
Анализ полученных результатов показал, что спиртовой экстракт всех исследуемых эфирных масел обладает большей антимикробной активностью, чем масляный. Исключение составили мята колосистая Медовая пасека, базилик Арарат, для которых масляные экстракты оказались более эффективными и базилик Лимончик, для которого эффективность и масляного и спиртового экстрактов оказались одинаковы.
Среди образцов эфирных масел группы «Этанол» наиболее высокую антимикробную активность показали эфирные масла тимьяна Лимонного сабсолютно лучшим результатом 96 %, атакже тимьяна Медовый аромат, базилика Изумруд и мяты Ментол с показателями отсутствия бактериального роста 88 %. Лидерами антимикробной активности среди образцов группы «Масло» стали эфирные масла мяты колосистой Медовая пасека (92 %), базилика Арарат (88 %) и базилика Лимончик (84 %).

Выявление потребительских предпочтений. Аромадегустация
Помимо антимикробных свойств, немаловажную роль играют органолептические свойства эфирных масел. Для получения информации о предпочтениях мы провели аромадегустацию среди одноклассников, их родителей и учителей лицея.
Опрашиваемым было предложено оценить аромат 9-ти исследуемых видов растений. Образцы растений были помещены в пробирки и пронумерованы. Каждый участник мог проголосовать «за» любой образец оценкой от 0 до 3, если аромат понравился или аналогично «против», если аромат не понравился. Всего в аромадегустации приняло участие 20 человек. Итоги аромадегустации представлены в Таблице 3.
Таблица 3
Итоги аромадегустации
|
Название растения |
За |
Против |
Итого |
|
Базилик Арарат |
30 |
4 |
26 |
|
Мята овощная Ментол |
29 |
6 |
23 |
|
Мята колосистая Медовая пасека |
29 |
8 |
21 |
|
Тимьян овощной Ароматная грядка |
30 |
9 |
21 |
|
Тимьян овощной Медовый аромат |
27 |
7 |
20 |
|
Базилик Изумруд |
24 |
9 |
15 |
|
Тимьян Лимонный |
24 |
10 |
14 |
|
Базилик Лимончик |
25 |
12 |
13 |
|
Мята длиннолистная |
19 |
13 |
6 |
Лидером аромадегустации стал базилик Арарат , с результатом 26 голосов, у которого высокие результаты антимикробной активности (72 % в группе «Этанол» и 88 % в группе «Масло»). Участники высоко оценили мяту Ментол, мяту колосистую Медовая пасека, тимьян Ароматная грядка, тимьян Медовый аромат. А вот аромат тимьяна Лимонного, с рекордными показателями антимикробной активности, не нашел соответствующего отклика у участников, что подчеркивает важность баланса между эффективностью и органолептическими свойствами при выборе масла.
Таким образом при выборе того или иного эфирного масла можно руководствоваться не только его эффективностью, но и органолептическими свойствами.
Заключение
В процессе исследования был проведен эксперимент по получению эфирных масел методом экстракции с помощью этилового спирта и растительного масла из доступных сортов эфиромасличных растений и измерена их антимикробная активность. В качестве сырья были выбраны по три сорта базилика, мяты и тимьяна, неприхотливых в выращивании и уходе и обладающих антимикробными компонентами в составе.
Всего было получено и исследовано 18 видов эфирных масел и определена их антимикробная активность. В результате проведенного эксперимента нам удалось выяснить, что все полученные эфирные масла обладают различной антимикробной активностью. Самую высокую антимикробную активность показали эфирные масла тимьяна Лимонного, полученного с помощью экстракции этанолом и мяты колосистой Медовая пасека, полученного с помощью экстракции маслом. Мы выяснили, что эфирные масла, полученные методом экстракции этиловым спиртом, показывают более высокие результаты, чем те, что получены методом экстракции маслом.
Таким образом, поставленная цель оценить антимикробную активность эфирных масел, полученных из разных сортов базилика, мяты и тимьяна достигнута.
На основании результатов исследования сделаны следующие выводы:
- Все исследуемые эфирные масла обладают антимикробной активностью.
- Эфирные масла, полученные из разных сортов мяты, базилика, тимьяна имеют разную активность в отношении микроорганизмов.
Таким образом гипотеза научной работы подтверждена: эфирные масла, полученные из разных сортов базилика, мяты, тимьяна, обладают различной антимикробной активностью.
Проведенная в ходе эксперимента аромадегустация пробудила интерес лицеистов к эфирным маслам. Участники тестирования в процессе мероприятия узнали от нас много полезной и новой информации о выращивании эфиромасличных растений в домашних условиях, их разнообразии, а также о возможности изготовлении масел и их применении. Особенно актуальны эти знания будут в периоды острых респираторных заболеваний, когда применение антибиотиков не всегда оправданно и небезопасно.
Будьте здоровы!
Литература:
- Бойко, Н. Н. Эфирные масла. Целебные свойства растительных ароматов / Н. Н. Бойко. — М.: Родная страна, 2015. — 336 с. — Текст: непосредственный.
- Буренина, И. А. Основные методологические принципы применения ароматерапии в восстановительном лечении / И. А. Буренина. — Текст: непосредственный // Вестник современной клинической медицины. — 2009. — № Т. 2, вып. 2. — С. 49.
- Всемирная, о. з. Антимикробная резистентность / о. з. Всемирная. — Текст: электронный // who.int: [сайт]. — URL: https://www.who.int/news-room/fact-sheets/detail/antimicrobial-resistance (дата обращения: 02.11.2025).
- Всемирная, о. з. Стратегия ВОЗ в области народной медицины 2014–2023 / о. з. Всемирная. — Текст: электронный // who.int: [сайт]. — URL: https://www.who.int/ru/news-room/questions-and-answers/item/traditional-medicine (дата обращения: 02.11.2025).
- Государственный реестр сортов и гибридов сельскохозяйственных растений, допущенных к использованию. — Текст: электронный // gossortrf.ru: [сайт]. — URL: https://gossortrf.ru/registry/gosudarstvennyy-reestr-selektsionnykh-dostizheniy-dopushchennykh-k-ispolzovaniyu-tom-1-sorta-rasteni/ (дата обращения: 20.07.2025).
- Государственный реестр сортов и гибридов сельскохозяйственных растений, допущенных к использованию. — Текст: электронный // gossortrf.ru: [сайт]. — URL: https://gossortrf.ru/registry/gosudarstvennyy-reestr-selektsionnykh-dostizheniy-dopushchennykh-k-ispolzovaniyu-tom-1-sorta-rasteni/ (дата обращения: 02.11.2025).
- Корнеева, Алина Эфирные масла / Алина Корнеева. — Текст: электронный // МЕД инфо: [сайт]. — URL: https://med-info.ru/content/view/6989 (дата обращения: 20.09.2026).
- Науменко, Е. Н. Исследование антимикробной и противовоспалительной активности эфирных масел / Е. Н. Науменко. — Текст: непосредственный // Вестник новых медицинских технологий. — 2009. — № Т. XVI, № 3. — С. 34.
- Николаевский, В. В. Ароматерапия: справочник / В. В. Николаевский. — М.: Медицина, 2000. — 336 с. — Текст: непосредственный.
- Эфирные масла и их качество / В. С. Паштецкий, Л. А. Тимашева, О. А. Пехова [и др.]. — Симферополь: ИТ «АРИАЛ», 2021. — 212 с. — Текст: непосредственный.
- Пряные травы на подоконнике. — Текст: электронный // GreenInfo.Ru: [сайт]. — URL: https://www.greeninfo.ru/actual/index.html/Article/_/aID/5294 (дата обращения: 20.09.2025).
- Солдатченко, С. С. Ароматерапия. Профилактика и лечение заболеваний эфирными маслами / С. С. Солдатченко, Г. Ф. Кащенко, А. В. Пидаев. — 2-е изд., испр. и доп. — Симферополь: Таврида, 2002. — 136 с. — Текст: непосредственный.
- Туманова, Е. Ю. Энциклопедия эфирных масел (Жизнь без химии) / Е. Ю. Туманова. — М.: РИПОЛ классик, 2014. — 254 с. — Текст: непосредственный.

